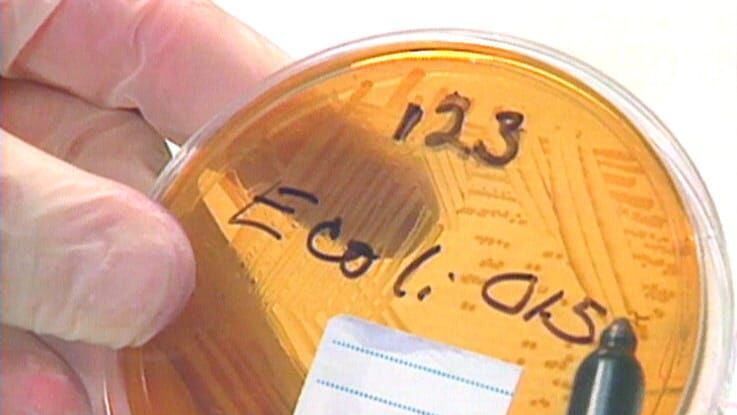

Verklag mich doch!
Ärger auf dem Kiez
Fr, 06.06.2025 | 11:40 - 13:45
Krimi (D 2012)
Der alleinerziehende Vater Thomas Mommsen führt einen erbitterten Kampf gegen seinen Vermieter Ralf Laubert. Der hat einen Investor für sein Wohnhaus an Land gezogen und will nun alle Mieter schnellstmöglich loswerden. Dafür sind ihm alle Mittel recht. Der Streit um das Wohnrecht eskaliert endgültig, als sich Ralf Lauberts Frau von ihrem tyrannischen Mann trennt und mit Thomas Mommsen zusammenkommt.
Gast
- Karsten Dusse (Rechtsanwalt, Autor)
- Matthias Klagge (Rechtsanwalt)
- Funda Bicakoglu (Juristin und TV-Staatsanwältin)
Wiederholung
 Di, 16.12.2025 | 14:05 - 15:00
Di, 16.12.2025 | 14:05 - 15:00Nächste Folgen
 Sa, 13.12.2025 | 05:15 - 06:20 (E: 398)
Sa, 13.12.2025 | 05:15 - 06:20 (E: 398) Sa, 13.12.2025 | 06:20 - 07:25 (E: 347/493)
Sa, 13.12.2025 | 06:20 - 07:25 (E: 347/493) Sa, 13.12.2025 | 07:25 - 08:30 (E: 426)
Sa, 13.12.2025 | 07:25 - 08:30 (E: 426) Sa, 13.12.2025 | 08:30 - 10:25 (S:1 E: 1)
Sa, 13.12.2025 | 08:30 - 10:25 (S:1 E: 1) Mo, 15.12.2025 | 05:50 - 06:40 (E: 19)
Mo, 15.12.2025 | 05:50 - 06:40 (E: 19) Mo, 15.12.2025 | 06:40 - 07:50 (E: 112/493)
Mo, 15.12.2025 | 06:40 - 07:50 (E: 112/493) Mo, 15.12.2025 | 07:50 - 08:40 (E: 104)
Mo, 15.12.2025 | 07:50 - 08:40 (E: 104) Mo, 15.12.2025 | 08:40 - 09:40 (E: 191)
Mo, 15.12.2025 | 08:40 - 09:40 (E: 191) Mo, 15.12.2025 | 09:40 - 10:55 (S:5 E: 45)
Mo, 15.12.2025 | 09:40 - 10:55 (S:5 E: 45) Mo, 15.12.2025 | 10:55 - 12:00 (E: 349)
Mo, 15.12.2025 | 10:55 - 12:00 (E: 349)